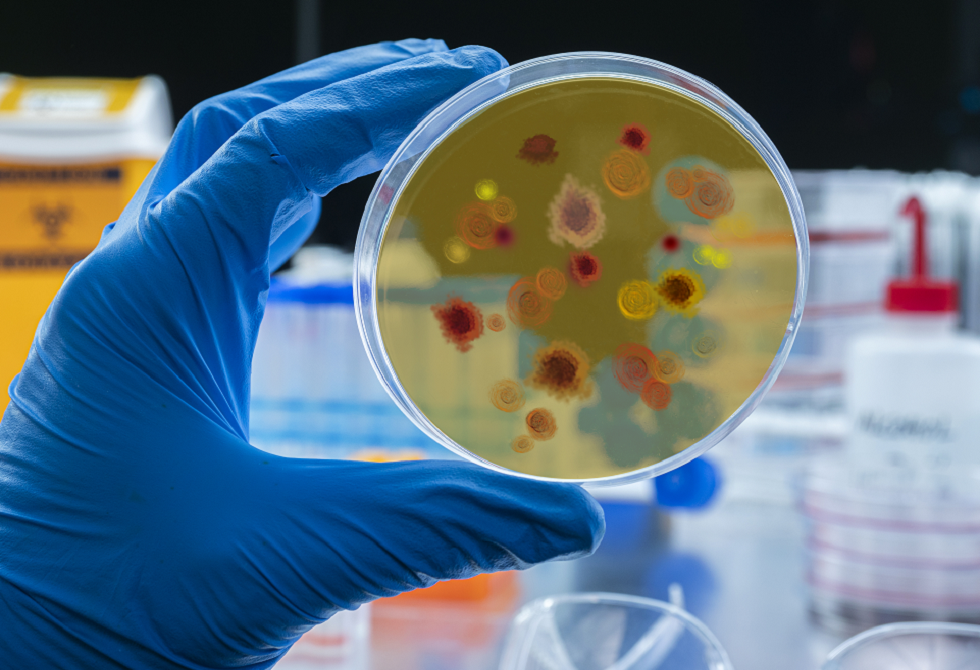

- كاتس: وجهت الجيش بالاستعداد لتوسيع عملياته في لبنان
- الجيش الإسرائيلي يستهدف موقعا آخر في برنامج إيران النووي
- أكراد إيران أمام معضلة خطرة.. المواجهة أم البقاء؟
- العراق.. مقتل نحو 20 من الحشد الشعبي في قصف جوي
- مسيرات على مطار الكويت.. وحادث في شارع الشيخ زايد بدبي
- حقيقة فيديو "هجوم إيراني على ناقلة نفط أمريكية بمضيق هرمز"
- حرب إيران: التضليل بألعاب الفيديو
- مصادر: تقييم مخابراتي أمريكي يستبعد انهيار النظام في إيران
- نظام ميروبس الأمريكي صائد المسيّرات الذكي
- "الاستراتيجية الأمريكية الإسرائيلية فشلت في هزيمة إيران بسرعة، ويتم الانتقال لخطة بديلة" - مقال في الغارديان
- 3 فرق عسكرية وتعبئة احتياطية.. الجيش الإسرائيلي يوسّع الحرب على لبنان
- كاتس يحذر عون: أوقفوا حزب الله أو سنأخذ الأراضي بأنفسنا
- "إعادة تموضع".. إجلاء 19 طائرة ركاب وشحن من مطار البحرين خلال يومين
- "نعرف أين يعيش وأين يشرب البيرة".. جنرال سابق في استخبارات كييف يهدد أوربان وعائلته
- الدفاع الروسية: إحباط هجوم أوكراني استهدف محطة لضخ الغاز الروسي إلى تركيا
- قرقاش: نقف موقفاً صلباً وثابتاً في مواجهة عدوان إيران
- الهجمات على الخليج.. حريق في البحرين واستهداف مطار الكويت
- موسكو.. الحكم بالسجن المؤبد على منفذي الهجوم الإرهابي على مسرح "كروكوس"
تنسيق مصري سعودي لمواجهة التصعيد العسكري في المنطقة
أجرى وزير الخارجية المصري بدر عبد العاطي اتصالا هاتفيا مع نظيره السعودي الأمير فيصل بن فرحان، بحثا خلاله التصعيد العسكري المستمر في المنطقة.
وخلال الاتصال، مع الأمير فيصل بن فرحان، جدد الوزير عبد العاطي التأكيد على موقف مصر الثابت والداعم بقوة للمملكة العربية السعودية وللأمن القومي العربي، مشدداً على تضامن القاهرة الكامل مع الرياض في مواجهة أي تحديات تمس أمنها.
كما أدان عبد العاطي بأشد العبارات الاعتداءات التي استهدفت سيادة وأمن عدد من الدول الشقيقة والصديقة، مؤكداً أنه "لا مبرر لتلك الاعتداءات"، ومطالباً بضرورة الالتزام الصارم بمبادئ حسن الجوار واحترام سيادة الدول.
وعلى صعيد آخر، تطرق الجانبان إلى ملف إجلاء الرعايا المصريين، حيث نقل عبد العاطي تقدير الدولة المصرية للدعم اللوجستي والتسهيلات الكبيرة التي قدمتها السلطات السعودية لضمان نجاح عمليات الإجلاء في ظل الظروف الراهنة والمعقدة التي تمر بها المنطقة.
وفي قراءة للمشهد الميداني، حذر وزير الخارجية المصري من التداعيات الكارثية لاتساع رقعة الصراع وانزلاق المنطقة إلى دائرة عنف مفرغة، مؤكداً أن استمرار هذا النهج يضع الأمن والسلم الدوليين على المحك، ويواجه المنطقة بتحديات جسيمة قد لا تحمد عقباها.
وفي ختام المشاورات، توافق الوزيران على ضرورة حشد الجهود الإقليمية والدولية لخفض حدة التصعيد بشكل فوري، مع تغليب المسارات السياسية والاحتكمام لغة الدبلوماسية والحوار. واعتبر الجانبان أن الحلول السياسية هي السبيل الوحيد لمنع انزلاق الإقليم نحو مواجهات شاملة وحالة من الفوضى التي قد تعصف باستقرار شعوب المنطقة.
المصدر: RT
 المصدر:
روسيا اليوم
المصدر:
روسيا اليوم